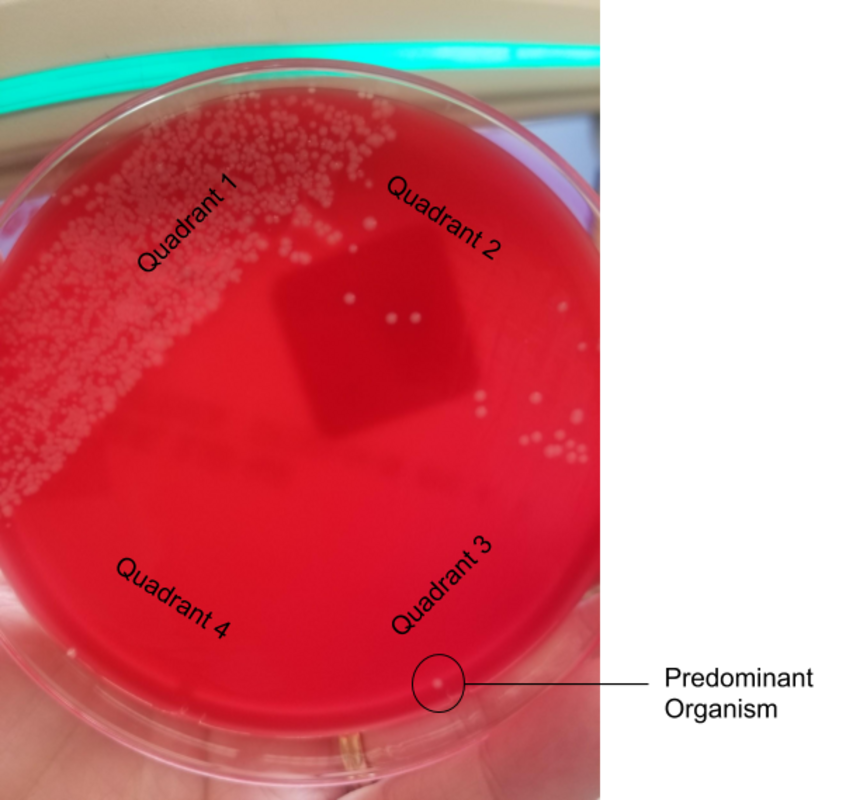
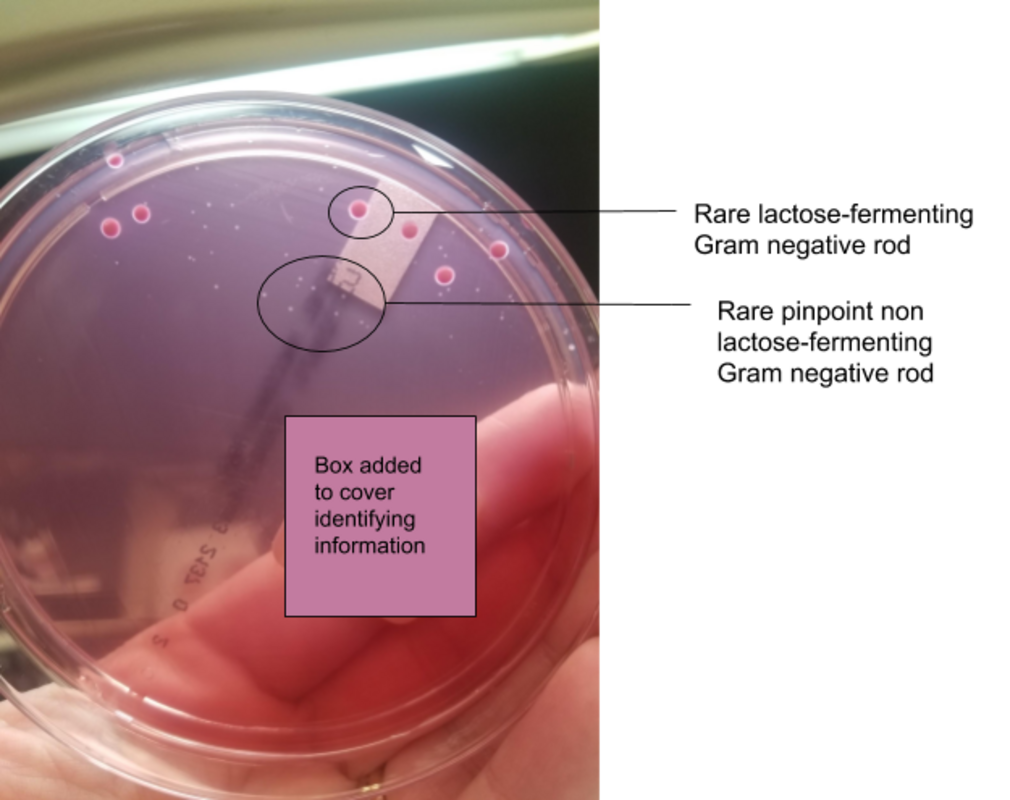
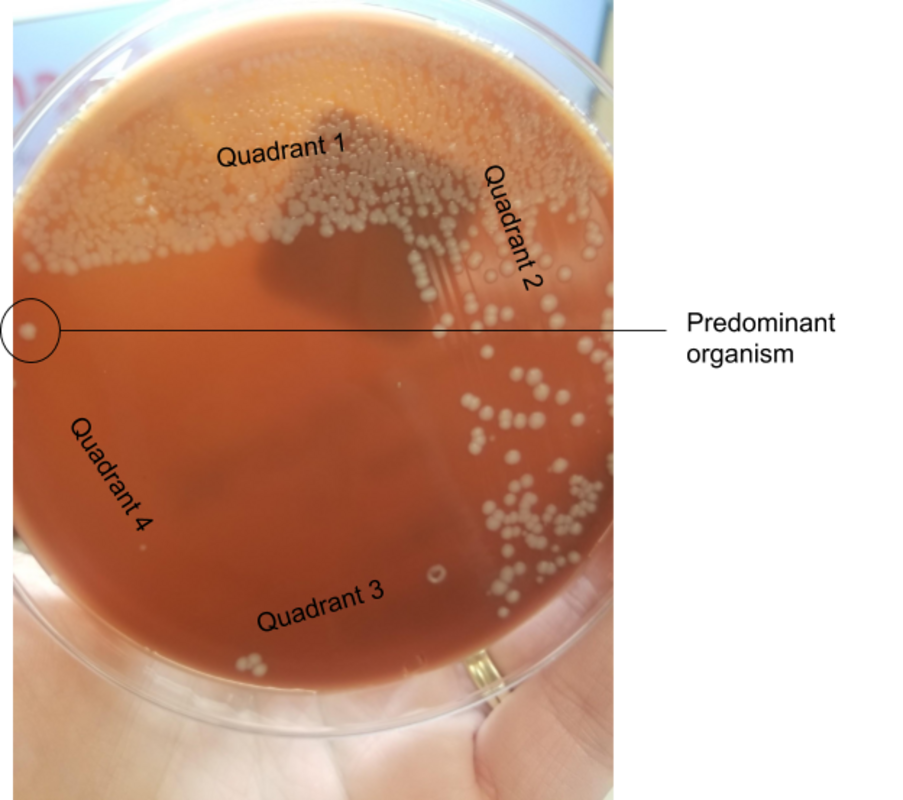
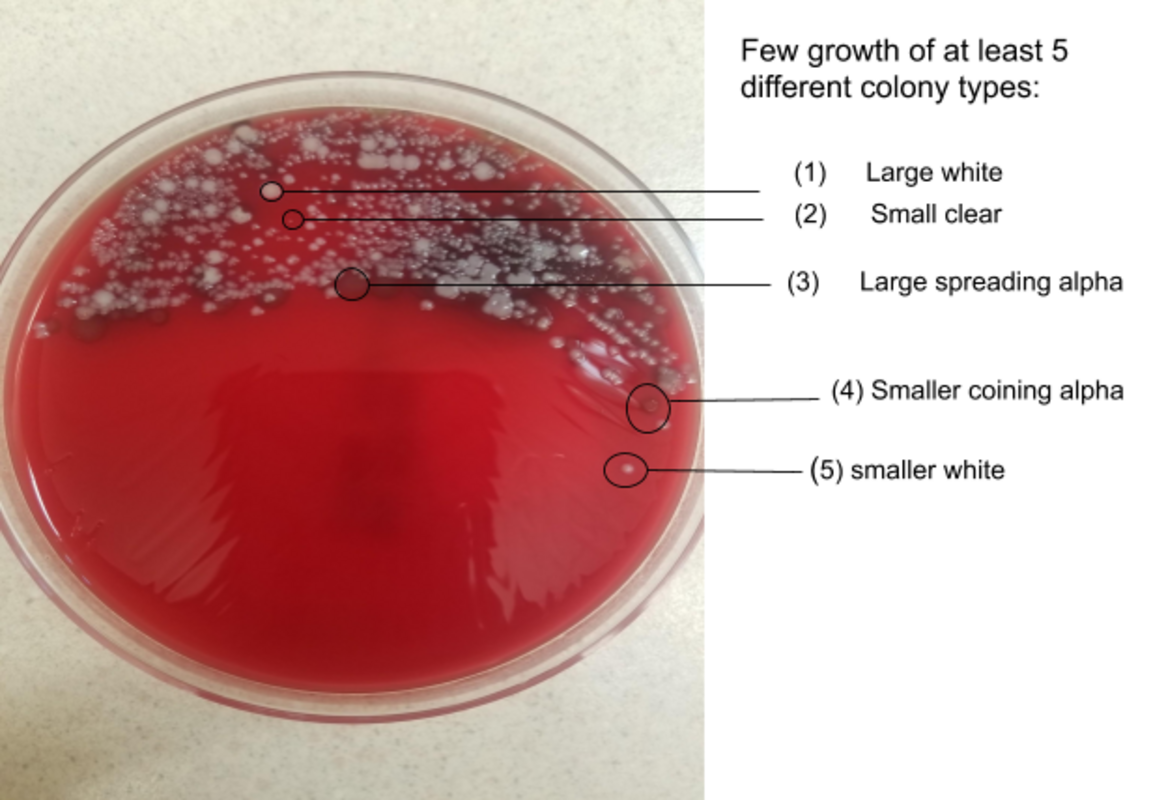
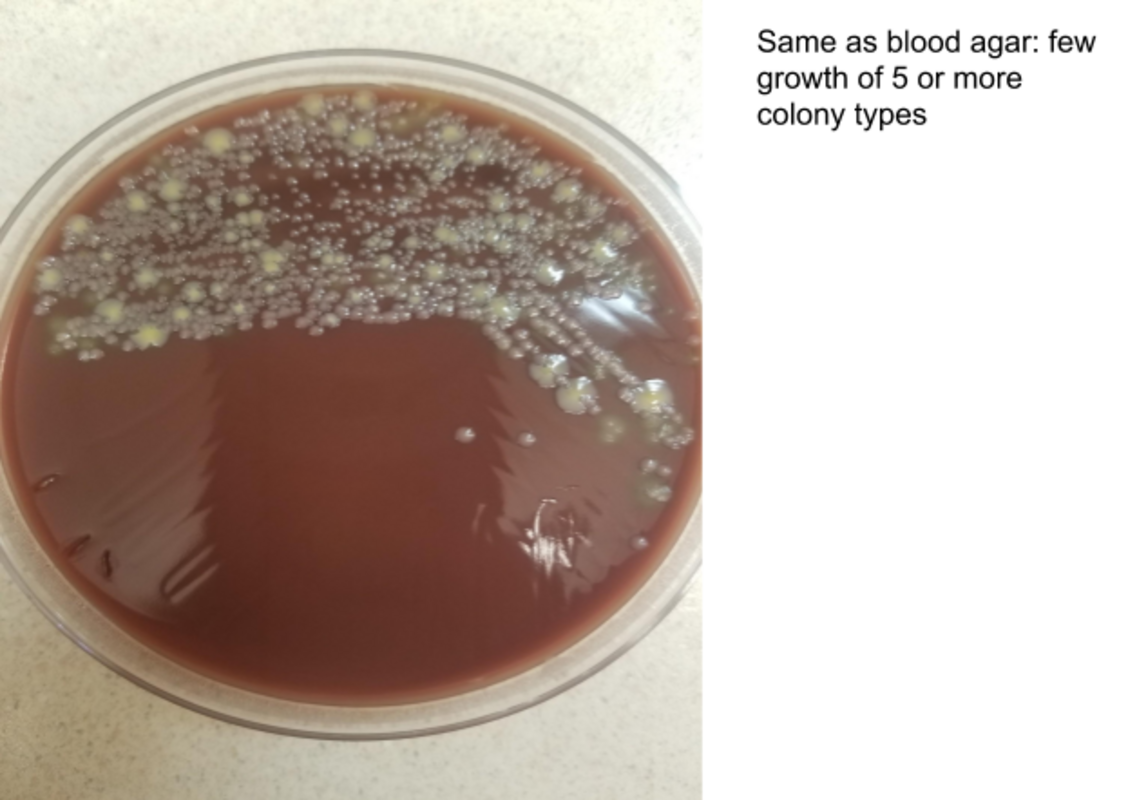

Искусственная вентиляция легких - это мера, спасающая жизнь тысячам пациентов каждый год, но пациенты, которым проводится эта операция, подвержены повышенному риску развития тяжелого состояния, называемого вентилятор-ассоциированной пневмонией (VAP).
VAP является второй по распространенности внутрибольничной инфекцией в отделениях интенсивной терапии и самой распространенной причиной нозокомиальной инфекции, приводящей к смерти пациентов в критическом состоянии. Серьезные последствия этого заболевания требуют быстрого и точного диагностического тестирования, однако золотого стандарта не существует.
Критерии, разработанные Центрами по контролю заболеваний (CDC) США, рекомендуют 3 метода диагностики VAP: бронхоальвеолярный лаваж (БАЛ), биопсия легких и трахеальный аспират. Из этих трех методов проще (и потенциально безопаснее) собирать образцы трахеального аспирата, но они имеют низкую диагностическую специфичность для VAP и редко позволяют отличить колонизирующую микробиоту от микробиоты, вызывающей инфекцию.
Диагностическая неопределенность заставляет врачей проводить эмпирическое лечение VAP, независимо от того, подтверждено ли наличие VAP у пациента или нет. В конечном итоге, предполагаемая VAP приводит к высокому использованию ресурсов и является наиболее распространенной причиной эмпирического применения антибиотиков в отделении интенсивной терапии. Это чрезмерное использование связано с появлением и распространением антибиотикорезистентных организмов в отделениях интенсивной терапии как взрослых, так и педиатрических учреждений. Несмотря на то, что метод культивирования трахеального аспирата недостаточно точен в диагностике VAP, у клиницистов остается мало выбора, кроме как использовать его, учитывая, что другие методы диагностики ограничены, а другие типы образцов получить сложнее.
Сокращение количества дней ИВЛ на одного пациента может сделать аппараты ИВЛ доступными для следующего нуждающегося пациента быстрее, а осторожная интерпретация результатов исследования культуры трахеального аспирата может предотвратить ненужные побочные эффекты от применения антимикробных препаратов.
Критерии отбора образцов мокроты широки и не универсальны, но они содержат алгоритмы, которым должны следовать лаборатории, чтобы предотвратить культивирование образцов, сильно контаминированных орофарингеальной флорой. В целом, критерии предполагают, что образец с большим количеством эпителиальных клеток, окрашенных по Граму, является контаминированным и, скорее всего, неприемлем для культивирования. Чтобы поддержать использование этих критериев, Коллегия американских патологов (CAP) при проверке клинической лаборатории на соответствие требованиям требует следующего:
1.Окрашивание по Граму должно проводиться регулярно для определения приемлемости образца и использоваться в качестве руководства для культурального исследования. Это должно быть задокументировано в лабораторных процедурах.
2.Лаборатории должны предоставить доказательства того, что они используют определенную форму критериев отбора окрашенных по Граму образцов и не культивируют образцы, которые считаются неприемлемыми по этим критериям.
В настоящее время не существует стандартов для лабораторной обработки культур трахеального аспирата. Два исследования, проведенные в 1990-х годах, предложили критерии отклонения образцов трахеального аспирата, окрашенных по Граму, с >10 клетками сквамозного эпителия или отсутствием организмов, обнаруженных при окраске по Граму, для взрослых и отсутствием микроорганизмов при окраске по Граму для педиатрических пациентов. Однако методические принципы так и не были установлены, и в результате эти культуры остаются ненадежными, вариабельными и дорогостоящими.
Культуры трахеального аспирата: проблемы
Итак, что же такого сложного в этих культурах? Дело в том, что несоответствия начинаются со сбора образцов и продолжаются вплоть до составления отчетов о чувствительности.
1.Использование линейного отсоса для сбора образца. Техника линейного отсоса собирает слизь из закрытой системы трахеальных трубок, которые были подсоединены к пациенту с момента подключения его к аппарату ИВЛ. Частота положительных культур значительно выше при использовании линейного отсоса по сравнению с использованием стерильного катетера для отсасывания. Это обычная практика для многих клиник, и при использовании этого метода больше вероятность собрать биопленкообразующие организмы, которые колонизируют пластик, что приводит к недостоверным результатам, позволяющим предположить, что у пациента пневмония, вызванная одним из этих условно-патогенных микроорганизмов.
2.Транспортировка образцов. Образцы должны быть доставлены в микробиологическую лабораторию как можно скорее после сбора, желательно в течение 2 часов. Если немедленная транспортировка невозможна, образцы следует охладить, чтобы улучшить выделение патогенов. Многие организмы чувствительны к изменениям температуры или задержкам в тестировании. Кроме того, рост прихотливых (но важных) организмов может быть подавлен ростом не прихотливых организмов в образце до того, как он будет культивирован в лаборатории, что приведет к недостоверным результатам культивирования. В некоторых лабораториях существуют требования к транспортировке образцов для культивирования трахеального аспирата, в других - нет.
3.Использование физраствора во время сбора и/или обработки образцов. Влияние физраствора на качество образцов зависит от времени транспортировки, обработки и методов культивирования. Доказано, что солевой раствор со временем повреждает или убивает определенные бактерии, что может оказать значительное влияние на то, что вырастет в культуре. Кроме того, использование физраствора для забора образцов трахеального аспирата или во время обработки образца приводит к его разбавлению. Если количество физраствора, использованного для забора образца, неизвестно, а в лаборатории будет использоваться количественное культивирование, то количество колоний, полученное из культуры, скорее всего, будет неточным.
4.Критерии отбора по Граму. Как упоминалось выше, существуют рекомендации по отбору по Граму для образцов мокроты, но не для образцов трахеального аспирата. Критерии отбора различаются в разных лабораториях, и это приводит к непоследовательности в культивировании, отчетности и общем управлении культурами трахеальных аспиратов. Отсутствие проверки качества путем использования критериев окрашивания по Граму приводит к культивированию некачественных образцов и результатам культивирования, которые вводят клиницистов в заблуждение.
5.Количественные и качественные методы культивирования. В нескольких исследованиях изучалась полезность количественных и качественных методов культивирования, однако дизайн и результаты исследований различны. Как и в отношении многих других компонентов процесса культивирования трахеального аспирата, руководство и универсальные рекомендации по культивированию образцов не разработаны.
6.Идентификация организмов, отчетность и тестирование на чувствительность к антибиотикам. Понимание роли нормальной респираторной микробиоты в развитии VAP является невероятно сложной задачей. Хотя присутствие какого-либо организма в культуре может просто указывать на колонизацию, эти колонизирующие организмы, как правило, также склонны вызывать пневмонию. В разных лабораториях сообщают о разных организмах по-разному. Микробиологам приходится идти по тонкой грани между завышенными данными о микроорганизмах (что может привести к ненужному применению антибиотиков и увеличению продолжительности пребывания в стационаре) и заниженными данными, в которых может не упоминаться о наличии микроорганизма, вызывающего серьезное заболевание. Это справедливо и для тестирования на чувствительность, которое следует предлагать только в тех случаях, когда предполагается, что сообщенный организм является причиной инфекции и применение антибиотиков оправдано.
Примеры из реальной жизни о сложных культурах трахеального аспирата
Пример 1
Результаты окрашивания по Граму:
- Нет полиморфноядерных клеток.
- Нет сквамозных эпителиальных клеток.
- Организмы не обнаружены.
Данный образец был окрашен полуколичественным методом (четыре квадранта, где рост отмечался как редкий (Q1), немногочисленный (Q2), умеренный (Q3) или интенсивный (Q4)). Образец был помещен на кровяной, шоколадный и МакКонки агары. После 24 часов инкубации на чашках наблюдался следующий рост:
Чашка с кровяным агаром показывает 4 квадранта посева. Белая колония растет в третьем квадранте, что делает ее преобладающим организмом при умеренном росте.
Фото: Andrea Prinzi
На агаре МакКонки видны 4 квадранта посева. Основной квадрант содержит точечные неферментирующие лактозу грамотрицательные палочки, а также более крупные ферментирующие лактозу грамотрицательные палочки. Фото: Andrea Prinzi
На чашке с шоколадным агаром видны 4 квадранта посева. Большая белая колония растет в четвертом квадранте, что делает ее преобладающим организмом с интенсивным ростом.Фото: Andrea Prinzi
Окраска по Граму для этой культуры была совершенно не выразительной, не показывая ни воспалительных клеток, ни эпителиальных клеток, ни организмов. Однако чашки рассказывают другую историю. На чашке с кровью наблюдается умеренный рост белой колонии (стафилококка), которая является преобладающим организмом, растущим в умеренных количествах. На шоколадном агаре наблюдается то же самое, за исключением того, что стафилококк растет в большом количестве. На агаре МакКонки наблюдается редкий рост как ферментирующей лактозу грамотрицательной палочки, так и не ферментирующей лактозу грамотрицательной палочки.
- Исходя из первоначального окрашивания по Граму, стоило ли вообще брать этот образец для культивирования?
- Ни один из организмов не был виден в первоначальном окрашивании по Граму, но есть преобладающий организм, и он растет в значительных количествах. В связи с этим фактом, вероятно, что организм будет полностью идентифицирован и зарегистрирован.
- Если организм полностью идентифицирован и зарегистрирован, следует ли проводить тест на чувствительность?
- В этой культуре растут грамотрицательные палочки. Однако они растут в незначительном количестве, не являются преобладающими и не были видны при окраске по Граму. Зная, что сообщение о грамотрицательных палочках, как правило, побуждает клиницистов к проведению терапии, следует ли вообще упоминать о них? Или их следует отнести к нормальной микробиоте верхних дыхательных путей?
- Если сообщается о грамотрицательных палочках, следует ли проводить тест на чувствительность?
В этом случае можно начать эмпирическую антимикробную терапию, если у пациента есть факторы риска VAP. Кроме того, схема лечения будет варьировать в зависимости от риска развития у пациента инфекции, вызванной резистентным к антимикробным препаратам микроорганизмом, недавних инфекций или истории предыдущих инфекций, тяжести заболевания и распространения местных паттернов чувствительности в данном учреждении.
Эмпирическая терапия часто направлена на лечение метициллин-резистентного золотистого стафилококка (MRSA), а также Pseudomonas aeruginosa. После получения результатов культурального анализа часто команда по управлению лечением должна поощрять деэскалацию антибиотиков, если терапия слишком широкая или ненужная. Хотя грамотрицательные палочки в этой культуре, скорее всего, незначительны, клиницисту может быть трудно отказаться от лечения Pseudomonas после получения сообщения о грамотрицательных палочках, не ферментирующих лактозу. Неоправданное применение этих антибиотиков может привести к осложнениям, таким как инфекция Clostridioides difficile, и способствовать распространению резистентных к антимикробным препаратам организмов.
Пример 2
Результаты окрашивания по Граму:
- Обильные полиморфноядерные клетки (количественное определение с использованием объектива 100X).
- Редкие сквамозные эпителиальные клетки.
- Редкие парные грамположительные кокки.
Этот образец был исследован методом полуколичественного посева (четыре квадранта, в которых рост отмечался как редкий, немногочисленный, умеренный или обильный). Образец был посеян на кровяной, шоколадный и МакКонки агары. После 24 часов инкубации на чашках наблюдался следующий рост:
Чашка с кровяным агаром с 4 квадрантами. Рост наблюдается во втором квадранте, при этом нет доминирующего организма, растущего больше чем другие. Имеется по крайней мере 5 различных типов колоний, что свидетельствует о смешанной флоре верхних дыхательных путей. Фото: Andrea Prinzi
Чашка шоколадного агара с 4 квадрантами посева. Рост наблюдается во втором квадранте, при этом нет доминирующего организма, растущего больше других. Имеется по крайней мере 5 различных типов колоний, что свидетельствует о смешанной флоре верхних дыхательных путей. Фото: Andrea Prinzi

Агар МакКонки без бактериального роста. Фото: Andrea Prinzi
Оригинальное окрашивание по Граму этого образца в некоторых лабораториях может считаться относительно показательным. Имеется значительное количество полиморфноядерных клеток, что может свидетельствовать об инфекции. Однако значение этих клеток в окраске по Граму оспаривается в литературе, поскольку они могут быть результатом других заболеваний или воспаления дыхательных путей в результате установки эндотрахеальной трубки. Редко встречаются клетки сквамозного эпителия, что позволяет предположить, что образец может быть приемлемого качества, и наблюдается один вид микроорганизмов, хотя и редкий. Исходя только из этого окрашивания по Граму, мы могли бы ожидать увидеть значительный рост одного вида микроорганизмов на чашках.
Однако этого не происходит. На чашках с кровью и шоколадным агаром наблюдается незначительный рост 5 или более типов колоний, при этом ни один конкретный организм не растет в большем количестве, чем другие. Это похоже на нормальную респираторную микробиоту без присутствия преобладающего патогена. Хотя несколько из 5 типов колоний имеют морфологию, соответствующую S. aureus или S. pneumoniae, они не являются преобладающими, и единственный организм, наблюдаемый при окрашивании по Граму, был редким.
- S. pneumoniae и S. aureus являются распространенными причинами VAP, но они также являются колонизаторами ротоглотки. Необходимо ли указывать их рост в культуре, даже если они не являются преобладающими?
- Если сообщается об этих организмах, следует ли предлагать тест на чувствительность?
- Следует ли считать грамположительные кокки в окраске по Граму значимыми, несмотря на их малое количество?
В данном случае в культуре не было выявлено преобладающего возбудителя. Если бы каждый потенциальный возбудитель был отобран и идентифицирован (например, S. aureus и S. pneumoniae) независимо от количества, клиницистов можно было бы побудить к лечению такими препаратами, как ванкомицин (для борьбы с MRSA) и меропенем, интенсивными препаратами широкого спектра действия, которые могут вызвать селекцию резистентных возбудителей, вызвать побочные эффекты и привести к инфекции C. difficile при длительном применении. Если результаты посева будут представлены как "смешанная нормальная флора верхних дыхательных путей", клиницисты могут с большей вероятностью отказаться от эмпирического лечения и искать другие причины симптомов пациента.
Вероятно, ответы на эти вопросы и интерпретация этих культур будут разными у микробиологов, читающих эту статью. Хотя низкий уровень субъективности является нормальным явлением в микробиологической лаборатории, он чрезвычайно распространен в случае с культурами трахеального аспирата. Отсутствие стандартизации или рекомендаций по обработке и исследованию образцов представляет собой проблему как для микробиологов, так и для клиницистов, и подчеркивает необходимость будущих исследований и разработки рекомендаций в этой области.
Разработка стандартов и рекомендаций по сбору образцов, транспортировке, критериям выбора и отчетности по культурам аспирата трахеи приведет к более осмысленной интерпретации результатов и снижению неблагоприятных исходов для пациентов. Искусственная вентиляция - это спасающая жизнь мера, которая необходима для оказания реанимационной помощи. Важно, чтобы были приняты меры по предотвращению развития VAP, но также важно, чтобы эти меры не привели к неадекватному лечению или увеличению времени пребывания в стационаре. Правильное клиническое ведение таких пациентов будет ключевым фактором сокращения продолжительности пребывания в стационаре и предотвращения ненужных побочных эффектов. В долгосрочной перспективе разработка рекомендаций по аспирации трахеи может помочь устранить путаницу и обеспечить значимость и предсказуемость результатов диагностики.
